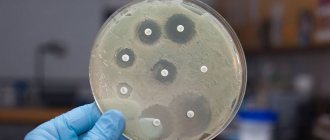

Infection with parasites is fraught with serious consequences: general intoxication of the body, poor health, disruption of the functioning of internal organs and systems.
Scraping for an eggworm is a sure way to determine the presence or absence of helminths in your body. The method is distinguished by its reliability, simplicity, and speed of obtaining results.
What to do in such a situation? To get started, we recommend reading this article. This article describes in detail methods of controlling parasites. We also recommend that you consult a specialist. Read the article >>>
You can take a scraping for worm eggs in a private diagnostic laboratory, for example, Invintro, as well as in a public clinic. Today we will talk about the features of taking scrapings for an eggworm. From the following article you will learn how to take the test correctly, as well as how to store stool for eggworm analysis in the evening.
What determines a stool test for worm eggs?
According to the World Health Organization (WHO), about 90% of the world's population suffers from parasitic diseases. The most common parasites are roundworms and pinworms. Based on this data, detecting and treating parasitic diseases is a very important step towards your health.
Worms are parasitic worms that live in the human body. The life cycle of many worms is designed in such a way that their eggs must be released into the external environment (this is a necessary condition for their maturation). The eggs leave the human body together with feces. Therefore, with helminthic infestation, the probability of detecting worm eggs in feces is quite high.
Normally, human feces should not contain any traces of parasites (eggs, larvae, worms and parts of parasites). In order to obtain the most reliable results, it is necessary to conduct 2-4 stool tests for helminth eggs with intervals of several days.
The three most common groups of parasites are:
- nematodes or roundworms: (these include: Roundworms, Whipworms, Necators, Duodenal Crookheads);
Roundworms (nematodes)
- trematodes or flukes: (these include: Schistosomes, Cat flukes, Liver flukes, Paradoxical leukochloridia);
- cestodes or tapeworms: (these include: Bovine tapeworm, Pork tapeworm, Broad tapeworm).
Tapeworms (cestodes)
Decoding the results
Analysis results can be obtained 1 to 5 days after delivery. The interpretation of the analysis is carried out by a pediatrician. Diagnosis is made based on the presence or absence of oviworm in the child's feces. Normally, no parasite eggs should be found in a small patient. The presence of eggs, larvae or their fragments indicates the development of a parasitic disease.
If the test result shows nothing, but the mother claims that the child has all the symptoms of helminthiasis, the doctor should order a repeat test. Collection of feces for worms should be carried out according to the following algorithm - 3 times every 2 days. This is due to the fact that parasites do not reproduce every day, but at intervals of 24 to 48 hours.
Types of stool tests
Modern medicine offers several methods by which feces are examined for worm eggs. Which one needs to be done and how to take it, the attending physician will explain. It all depends on the final goal.
A stool test for parasites can be prescribed either general or selective. You can also conduct a study of feces for the presence of intestinal pathology and changes in microflora. When a doctor recommends a stool test, he issues a special form (referral), which already indicates what exactly to look for.
Each type of research has its own characteristics, which also apply to preparation for them. Even how long a stool sample can be stored matters.
Parasites detected by microscopic examination
Laboratory tests of stool for worm eggs make it possible to determine the type of parasitic worm very accurately. Under a microscope, the difference between nematodes, tapeworms, flukes or tapeworms that infect the human body is clearly visible. A group of helminths is often found, including several types of parasites in the human body.
Naturally, we are not talking about an adult worm in microscopic studies, but about parts of the shells, eggs, larvae, and segments of worms. Detection of parasite eggs in feces allows us to establish with 100% accuracy the type of parasitic worm and make a diagnosis of helminthiasis.
In addition, microscopy analysis makes it possible to detect microorganisms of the order of protozoa:
- lamblia;
- dysenteric amoeba;
- oocytes – cyclosporidium.
A referral for laboratory tests that a potential patient needs to undergo is given by the therapist:
- For barrier analysis, including enterobiasis.
- In case of suspected helminthiasis.
Barrier or screening analysis
This analysis is carried out as part of a regular annual medical examination. Also, fecal microscopy is a mandatory analysis when examining a person entering work in the field of household services related to the sale of food products. The number of times a person goes to work, the number of times he will collect tests, since the results are valid for an extremely short period of time.
In addition, employees of children's institutions are required to undergo regular medical examinations, an integral part of which is a screening, or rapid type of analysis of feces.
Barrier analysis is also carried out when preparing certain types of documents:
- young children entering kindergarten;
- children of preschool and school age to visit the pool;
- categories of people undergoing planned hospitalization;
- for those who plan to be treated in a hospital;
- trade workers to obtain a health certificate.
Barrier analysis is a necessary type of microscopic examination for those who will have direct contact with other people.
Suspicion of helminthiasis
This is an unscheduled stool examination, the need for which arose based on symptomatic disorders of the human body. When the diagnostics of a particular organ, according to the patient’s complaints, did not give the appropriate result and the diagnosis is problematic, a detailed examination is carried out, in particular an analysis of stool.
Worms lead a parasitic lifestyle, affecting human tissues and internal organs, living in the intestines, bladder, and urethra. They can also be found in some areas of the brain, in the liver and heart, and in the lymph nodes. They can cause uncharacteristic symptoms that are difficult to diagnose.
Often, in cases of helminth infection of internal organs, only one stool examination is not enough to confirm helminthiasis of internal organs. To carry out a general set of diagnostics, it is necessary to collect sputum, bile, duodenal contents and other secrets of the human body , says infectious disease specialist Yu.G. Trubitsyna.
Also, microscopy of stool for ovuleworms is carried out in cases of unclear etiology of the inflammatory process in any organ and in the case of an unspecified nature of allergic reactions, as well as in cases of persistent acute viral respiratory diseases that arise out of “nowhere”.
How to collect
Drits Irina Alexandrovna. Parasitologist Helminth infections can lead to numerous health problems, shortening life by 15-25 years. Many parasites are extremely difficult to detect. They can be anywhere - in the blood, intestines, lungs, heart, brain. Symptoms of helminthic infestation can be confused with ARVI, gastrointestinal diseases and others. The main mistake in such cases is delay! If you suspect the presence of parasites, you need to contact a specialist. More information about modern methods of treating helminth infections is described in this interview with a doctor . If we talk about medications and self-treatment, then this antiparasitic complex .
Specialists from the laboratory recommend remembering and adhering to the following rules. It is strictly forbidden to do enemas 3 days before the tests. Only naturally obtained biomaterial is suitable for research. Before collecting feces, it is recommended to stop taking medications, including sorbents and laxatives, for 3 days.
If the patient takes any medications on an ongoing basis, the attending physician must be notified about this. The day before the procedure, it is prohibited to use rectal suppositories. When referred for some tests, the patient will have to adhere to a special diet for 7 days.
Storage containers
As a rule, it involves avoiding fatty and fried foods, pickles and smoked foods, and foods with a lot of spices and seasonings. These days, the basis of the patient’s diet should be fermented milk products and vegetables. If you are scheduled to take an occult blood test, you must limit your intake of foods containing iron.
To ensure that the analysis result is as accurate as possible, it is important to follow these rules:
- Feces are collected for analysis only after urination. If urine gets into the sample, the result may be distorted. This rule applies to adults and children.
- Before collection, it is necessary to carry out hygiene of the intimate area, including the anus. The procedure is carried out using warm water and regular soap.
- Defecation is carried out over a clean and dry container, after which part of the sample is transferred to a special sterile container. A sample container can be purchased at a pharmacy. It usually comes with a sterile plastic spoon.
- If biomaterial is collected from children, the sample can be collected directly from the diaper.
How to prepare for the analysis?
To increase the reliability of the result of a stool test for eggworms, it is necessary to follow certain rules before submitting it.
It makes no sense to examine feces for worm eggs in the following cases:
- When taking antiparasitic drugs and immediately after their course;
- After an X-ray examination using barium preparations;
- After oil enemas.
In all these cases, the probability of detecting helminth eggs approaches zero, and the results of the analysis may not be indicative.
Taking certain potent medications can also reduce the effectiveness of studies. If they are not vital, then they must be stopped 3 days before collecting stool for analysis.
If the patient is undergoing a course of treatment that cannot be interrupted, for example, a course of taking antibiotics, then it is better to postpone the stool test for helminth eggs until the end of the treatment, since under conditions of a changed environment in the intestines, the reproduction of helminths slows down and their eggs may not be detected.
Attention! If the patient has been treated with antibiotics, then a stool test for eggworm can be taken no earlier than 3 days after the end of the course.
It influences the research results and the composition of the food that a person ate on the eve of collecting biological material. When consuming foods that promote increased gas formation and loosening of the intestines, food masses quickly pass through the intestinal tract, and the likelihood of containing parasite eggs in the feces is reduced. Therefore, 1-2 days before collecting stool for analysis for worm eggs, it is recommended to exclude from the diet foods that cause intestinal weakening.
The set of these products is individual for each person, but, in general, they include:
- Fresh and sauerkraut;
- Fresh beets;
- Apricots, plums;
- Prunes;
- Grape;
- Persimmon;
- Kefir;
- Cucumbers, zucchini, pumpkin;
- Legumes;
- Watermelon melon.
It is also not recommended to consume foods that color feces in uncharacteristic colors - the already mentioned beets, blueberries, cherries, black currants.
By adhering to these simple rules, you can significantly increase the likelihood of identifying a helminthic infestation and begin its treatment in a timely manner.
What are the rules for collecting stool for analysis?
If all the rules for preparing for the examination of stool for the presence of parasite eggs, indicated above, have been followed, then a sample of the material can be taken for analysis. Usually this moment raises many questions: how much feces is needed for analysis of the eggworm, what are the rules for collecting it, is it possible to store the collected material, etc. Let's look at the answers to these questions in detail.
In what container should I collect stool?
Laboratories do not accept stool in matchboxes or other cardboard boxes for analysis; to collect the material, you can take a small glass container with a tight lid or buy a special plastic container for collecting stool at the pharmacy. This container is convenient because it is equipped with a spatula for collecting the sample and a tight-fitting lid that does not allow odor to pass through.
If the collection is carried out in home containers, then it is most convenient to do it with a disposable spoon. You can also use a cotton swab and a few matches. You cannot use wood chips and twigs brought from the street for this purpose, since they may contain parasite eggs, which will distort the analysis results.
Do I need to wash myself?
If, when collecting urine for analysis, it is necessary to wash to prevent secretions and microflora living on the genitals from getting into the biological material, then when collecting feces for analysis for worm eggs, it is not recommended to wash.
Some types of helminths (pinworms) lay eggs around the anus, and worm eggs from a previous bowel movement could also remain in the anus.
During the passage of feces, they may end up in the first portion of biological material, which increases the likelihood of detecting helminthic infestation.
Attention! If you need to donate stool for eggworm testing, the collection rules dictate that you do not wash yourself before the collection procedure. It's better to do this after it's finished.
How to properly collect stool for analysis?
It is necessary to defecate in a clean, dry pot or vessel. It is not allowed to “catch” material from the toilet water. It is also necessary to ensure that urine does not get on the feces; you need to empty your bladder in another place.
The material is collected from several places in the feces: from the initial section, from the middle and end, from the surface and depth. The stool sample for analysis should be approximately the size of a walnut. Immediately after collection, the container must be tightly closed to prevent the material from airing or drying out.
How can you induce a bowel movement?
Physiological processes are not always amenable to conscious control; it is almost impossible to force the intestines to release waste products on demand. The easiest way to collect stool for analysis for worm eggs is for those people who are used to emptying their bowels in the morning after waking up, since laboratories, as a rule, accept biological materials for analysis in the morning.
To stimulate the intestines to empty, it is not recommended to use enemas or anal suppositories, since this reduces the likelihood of obtaining a reliable test result for the eggworm, which is already not too high.
You can get morning bowel movements naturally by following these recommendations:
- After waking up, drink a glass of cool water;
- After 15-20 minutes, have breakfast;
- If you don’t feel like going to the toilet within 20 minutes after breakfast, do light self-massage of the abdomen and exercises to enhance intestinal motility.
Self-massage of the abdomen is performed while lying on your back. Having relaxed your stomach, stroke around the navel in a spiral, the direction of movement is clockwise. It is more convenient to do this by clenching your fingers into a fist.
After the massage, do the following exercises to stimulate the intestines to empty:
- Standing on all fours, draw in and relax your stomach;
- Lying on your back, pull your knees towards your chin and then return to the starting position.
If all of the above measures do not have an effect, this means that material for analysis will have to be collected in advance.
But before moving on to the next point of this article and finding out how long you can store feces for worm eggs, remember the method recommended above for improving intestinal motility. By using it daily, you will quickly accustom your body to regular morning bowel movements, which will undoubtedly be very beneficial for your health.
How long can the collected material be stored?
It is necessary to store a sample of material for analysis for helminth eggs in a tightly closed container, tied in a plastic bag, in the refrigerator at a temperature of +6-10°C. With this storage, the feces will not dry out, worm eggs, if present in the sample, will not change and will be available for identification. Storage time should not exceed 8-12 hours.
How to collect stool for analysis from a child?
The rules for collecting stool for analysis for eggworm in children, as well as preparing for it, are exactly the same as for adults. The exceptions are children who are breastfed, as well as babies wearing diapers.
Since the baby’s stool depends on the mother’s nutrition, she should, 1-2 days before collecting stool for analysis, exclude from her diet foods that cause weakening of the child’s intestines.
To test for helminth eggs, you should not collect stool from a diaper. The child should empty his bowels into a potty or onto a clean, dry diaper. Make sure that urine does not come into contact with the test material.
To take stool for analysis, it is forbidden to induce defecation in children using an enema, anal suppositories, or a thermometer lubricated with Vaseline. All this leads to a decrease in the reliability of the analysis. You can stimulate defecation by lightly massaging the child’s abdomen in a clockwise direction, doing exercises with tucking the knees to the chin, and laying it on the stomach.
How to store a sample before the laboratory
If the biomaterial was collected at night before bedtime, the patient must adhere to certain rules that will help preserve the sample until the morning.
If possible, defecation should be done as late as possible so that the number of hours between bowel movement and delivery of the collected material to the laboratory is minimal.
You also need to remember the following:
- To maximize the shelf life of the sample, it is recommended to collect biomaterial in a special sterile container, which is sold in pharmacies. It is better to open such a container immediately before collecting the material. After this, the container must be tightly closed with a lid.
- How long a sample can be stored depends on the type of test. The maximum shelf life of feces is 8 hours. For some tests, for example, for enterobiasis, the shelf life is even shorter - up to 5-6 hours. There is no point in storing the sample longer than this time, since the result will be unreliable.
- It is recommended to keep feces collected in the evening in the refrigerator. Permissible temperature is from -4 to +8 degrees. In this case, the container cannot be placed on the lower and especially on the upper shelves. It is best to place the container on the middle shelf of the refrigerator, since this is where the proper temperature is maintained.
Selection of capacity
To collect stool, the container does not need to be sterilized. Therefore, a small glass jar that closes hermetically is suitable for these purposes. This will save some of the money and time it would take to go to the pharmacy. But the store-bought container also has its advantages - it comes with a special small spoon that makes it easier to collect excrement.
When choosing a container, you should keep in mind that the laboratory does not accept tests in matchboxes or paper boxes.
When the stool is collected, the container must be labeled. To do this, you must indicate your last name, first name and date of collection of the analysis.
Features of storage in the refrigerator
Many people are interested in how long feces can be stored at minimum temperatures. Experts recommend keeping it in the refrigerator for no more than eight, and preferably six, hours.
For different types of research, different deadlines are allowed:
- For helminths and their eggs – from 5 to 8 hours.
- For blood (occult) – from 5 to 6 hours.
- For coprogram – from 6 to 8 hours.
- For enterobiasis – from 5 to 8 hours.
It is not allowed to store feces for long periods of time for research.
To keep feces in the refrigerator in optimal condition, it is important that the temperature is no higher than eight and no lower than four degrees. For the occult blood test, the temperature should not exceed six degrees.
Store feces in a sealed container, placing it on the middle shelf.
What symptoms may indicate a worm infection?
A symptom that clearly indicates the presence of worms is itching and movement in the anus, especially noticeable in the evening and at night. This is typical for enterobiasis - pinworm infestation. Invasion by other types of helminths does not have such a clear and characteristic clinical picture; symptoms may be unexpressed, or also characteristic of many other diseases.
The following symptoms may cause suspicion of helminthiasis:
- Decreased appetite up to its complete absence;
- Flatulence and intestinal disorders;
- The presence of blood and mucus in the stool;
- Loss of body weight;
- Frequent headaches, sleep disturbances;
- Constant feeling of loss of strength;
- Pale skin;
- Weakening of the immune system, resulting in susceptibility to frequent colds;
- Grinding of teeth in sleep;
- Skin problems.
Preservation of feces for different types of diagnostics
The shelf life also depends on what kind of research needs to be done:
- Coprogram. Feces must be placed in a clean container (two teaspoons is the optimal volume of material for such diagnostics). They must be submitted for analysis within five hours. It is important that laxatives and cleansing enemas are not used before collecting stool.
- For helminths, E. coli, rotavirus and protozoa. Place the material in a container and hand it in within three hours.
- Biochemical study (for dysbacteriosis). It is advisable to deliver the feces to the laboratory on the day of delivery. If this is not possible, you can keep the collected material in the freezer. It should not be defrosted. Information about the type of stool (constipation or diarrhea, with the use of laxatives, without any features) is provided with the sample.
- For blood (hidden). When collecting stool, do not use medications with laxative effects or enemas. It is recommended to deliver the mass to the laboratory within five hours.
- Microbiological research. It is advisable to submit the material after collection within 180 minutes.
- For enterobiasis (to identify pinworms and taeniids). They donate not stool, but a smear taken from the folds of the anus. The wand used to take the test must be returned within four hours.
- For carbohydrates. The mass should be given no later than six hours from the moment of collection in order to obtain the most reliable result.
A more accurate interpretation of any type of analysis can be obtained if the stool is sent for research as quickly as possible.
Necessity and sufficiency of scraping for enterobiasis
A scraping is taken from a child or adult to determine the presence of eggs of a type of parasite such as pinworms. The recommended measure on the part of doctors is universal medical examination for all age categories. It should be carried out once every six months, at least once a year.
Pinworms are the most common type of parasite, sometimes visible in feces to the naked eye. In such a case, getting tested is extremely necessary. Children and pet owners are especially susceptible to infection with this type of worm. The analysis is not done once, but in several stages. Feces are collected every 2 days, at least three times.
Scraping indicators are considered normal if there are no pinworm eggs in the feces.
Preparatory stage before scraping
There is no need to prepare in any particular way for scraping for enterobiasis. The main recommendation before taking the test is to adhere to two positions: do not defecate in the morning and avoid morning washing. This will allow us to conduct research on enterobiasis more reliably.
The process of scraping for enterobiasis occurs as follows:
- It is recommended to collect material as soon as the person wakes up.
- Collection of stool can be carried out both at home and at the place of reception of the stool being tested for enterobiasis.
- To collect a smear or scraping, special items are purchased, which are a test tube or a glass slide, sold in any pharmacy; they must be equipped with a sticker indicating the patient’s name.
Collection of material for enterobiasis should be carried out in accordance with simple instructions:
- Wear rubber gloves, purchased in advance at any pharmacy.
- Open the test tube container and remove from it a special probe stick with cotton wool at the end.
- Spread the buttocks, exposing the anus, and run a cotton probe around it.
- Place the dipstick back into the test tube and seal with the stopper.
- Write your last name on the sticker.
- Submit the test tube to the laboratory.
Collecting material for enterobiasis using a glass slide is carried out using a different method:
- It is recommended to collect material for analysis on a glass slide, which, like a container or test tube, can be purchased at a pharmacy. A transparent adhesive tape is applied to the front of the glass.
- Wear gloves.
- Remove the adhesive tape with great care so that it does not stick to the gloves or surrounding foreign objects with the sticky side.
- Spread the buttocks apart and place the tape with the adhesive side on the anus for at least 2-3 seconds.
- Remove the tape and, without touching its surface, stick it onto a glass slide.
- Display your initials on the label and get tested for enterobiasis in the laboratory.
The test for enterobiasis is done quite quickly - the patient receives the result almost the next day, unless, of course, the material was submitted on the eve of the weekend. The analysis will be ready, but it will be possible to get an answer only at the beginning of the work week.
Differences in storing feces of an adult and a child
Children are usually unpredictable, and the exact time when they will have a bowel movement is very difficult to determine. Therefore, if parents are lucky enough to receive biological material in the morning, it should be immediately taken to the laboratory.
The permissible interval between collection and delivery of feces to the clinic is from one to three hours.
A child’s feces, collected the evening before delivery to the laboratory, can be stored in the refrigerator (at 4-6 degrees Celsius) for no more than eight hours. If the time period from collection to delivery exceeds 480 minutes, the material will be unsuitable for research.
An adult can store their feces for testing for up to three hours. If the material is in the refrigerator, then it can be handed in for another two days (but not later!).
However, it is important to understand that long-term storage may result in inaccurate results. Therefore, it is best to submit such material to the laboratory within six hours after collection. After this time, its biological properties begin to change .
Analysis of feces is reliable only if the material was correctly collected and all storage conditions were met. In addition, it is important to remember that there are some differences depending on the type of analysis. Therefore, it is important to familiarize yourself with the recommendations of specialists regarding the collection and storage of material.
When should you get tested?
A referral for a scatological examination for helminth eggs must be issued by a local pediatrician or family doctor in the following cases:
- when visiting a public swimming pool or sports sections;
- when preparing medical records;
- before registering a child for kindergarten or school;
- upon admission to the hospital.
The analysis results are valid for ten days. At the same time, this study should be taken quite seriously, since no one can be sure that the child is not infected with parasites.
Typically, such an examination is prescribed routinely in pediatric practice. Conducting an analysis in both children and adults is necessary if there are cats or dogs in the house, work activity associated with prolonged and frequent contact with animals, or suspicion of helminthiasis.
Preparation and conduct of the study
Preparation for this study includes:
- avoiding taking laxatives and administering rectal suppositories;
- discontinuation of medications that may affect the color of stool or intestinal motility.
All this must be done seventy-two hours before the start of the study.
The collected material is being examined in specialized laboratories. The laboratory assistant prepares a smear from the provided material, which is carefully examined under a microscope. As a result, both adults and their eggs and larvae are detected.
The norm when interpreting such tests is a negative result, which indicates the absence of parasites in the human body. The approximate time for carrying out the analysis is six days from the delivery of the material.
In some cases, a very small number of helminths are diagnosed and then the test is repeated to confirm a possible positive result. If the result is positive, the analysis form indicates those pathogens of helminthiasis that were identified.